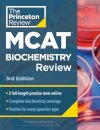
Princeton Review MCAT Biochemistry Review, 3rd Edition

Livros
Princeton Review MCAT Biochemistry Review, 3rd Edition
ISBN: 9780593518809
€ 55,90
Essentials of Perioperative Nursing
ISBN: 9781284079821
€ 195,90
Hospital Pharmacy Practice for Technicians
ISBN: 9781284030464
€ 116,90
Fascial Manipulation(r) - Stecco(r) Method the Practitioner's ...
ISBN: 9781912085019
€ 58,90
Nursing Practice
ISBN: 9781119800750
€ 60,90
Kinesiology Taping for Rehab and Injury Prevention
ISBN: 9781612435534
€ 17,90
The Royal Marsden Manual of Clinical Nursing ...
ISBN: 9781119532965
€ 63,90
The Student Nurse in the Diploma School ...
ISBN: 9783662392485
€ 65,90
Aphasia — A Social Approach
ISBN: 9781565931978
€ 131,90
Princeton Review MCAT Subject Review Complete Box ...
ISBN: 9780593518915
€ 291,90
Osteopathy
ISBN: 9780443073953
€ 81,90
Objective Structured Clinical Examination
ISBN: 9780273738978
€ 15,90
Pilates Applications for Health Conditions Volume 1
ISBN: 9781912085972
€ 95,90
The Age of Living Machines
ISBN: 9780393358261
€ 18,90
First Aid for the USMLE Step 2 ...
ISBN: 9781259862441
€ 87,90